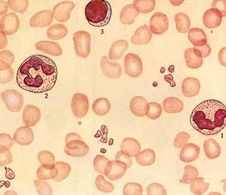
小兒自身免疫性溶血性貧血
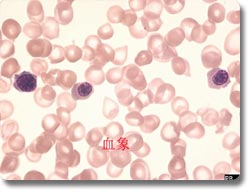
小兒自身免疫性溶血性貧血

基本概述
小兒自身免疫性溶血性貧血
小兒自身免疫性溶血性貧血發病原因
小兒自身免疫性溶血性貧血的分類有根據病因進行分類,根據抗體的種類進行分類和根據起病急緩和臨床經過分類。
1.根據病因分類 分為特發性AIHA與繼發性AIHA兩類,小兒患者以特發性者居多,約占70%。
(1)特發性:病因不明。
(2)繼發性:常見病因有: ①感染:可由細菌、病毒、支原體或疫苗接種等引起,病原體包括傷寒、鏈球菌、金黃色葡萄球菌、結核、肝炎病毒、巨細胞包涵體病毒、EB病毒、皰疹病毒、流感病毒、腺病毒、腮腺炎病毒、傳染性單核細胞增多症、水痘、風疹及肺炎支原體(非典型肺炎) 、螺鏇體屬感染(如鉤端螺鏇體病)等。 ②免疫性疾病:常見於系統性紅斑狼瘡、類風濕性關節炎、皮肌炎、特發性血血小板減少性紫癜、免疫缺陷病,無丙種球蛋白血症、異常丙種球蛋白血症和骨髓移植等。
 小兒自身免疫性溶血性貧血
小兒自身免疫性溶血性貧血藥物誘發的AIHA主要有3種類型: A.青黴素型:亦稱藥物吸附型。藥物吸附於紅細胞表面形成新的抗原,免疫系統製造抗體,通常是IgG與之結合而發生溶血。青黴素、先鋒黴素、四環素等所引起的AIHA均屬這一類型。 B.甲基多巴型(methyldopa type):α-甲基多巴引起的AIHA屬自身免疫性,60%見於HIA_B7。 C.免疫複合物型:這是由於IgM與藥物反應,激活了補體系統,C3b沉積於紅細胞表面,進而導致巨噬細胞對帶有C3b的紅細胞發生攻擊和吞噬。少數IgG抗體也可為冷凝型,類似於IgM,見於陣發性寒冷性血紅蛋白尿。這種抗體與紅細胞膜上的血型P抗原結合,通過激活補體而發生溶血性貧血。
2.根據抗體性質分類 分為溫抗體型和冷抗體型兩類。溫抗體型在37℃時作用最強,又分為溫性不完全抗體和溫性溶血素。溫性不完全抗體是一種不完全抗體,為IgG型;溫性溶血素為IgM型。冷抗體型於4℃時作用最強,是一種完全抗體,它又可分為冷凝集素和冷溶血素。前者是IgM型,能引起冷凝集素綜合徵;後者是IgG型,能引起陣發性寒冷性血紅蛋白尿。兩類又各有混合型。
3.根據起病急緩和臨床經過分類 分為急性型、亞急性型和慢性型三種類型,急性型和亞急性型多見於嬰幼兒,慢性型多見於兒童和青少年。
發病機制
1.紅細胞自身抗體的產生機制 抗紅細胞自身抗體的產生機制尚未完全清楚。主要有以下幾種觀點:
(1)紅細胞抗原性發生改變:正常機體對自身紅細胞不產生抗體。病毒感染或某些化學物質與紅細胞膜結合後,使紅細胞的抗原性發生改變,從而產生自身抗體。
(2)免疫系統異常:由於某些因素的影響(如免疫缺陷、惡性腫瘤、胸腺疾病、遺傳基因突變等),引起機體免疫監視功能紊亂,使體內免疫活性細胞喪失對自身紅細胞的識別能力,從而產生自身抗體。由於抑制性T細胞減少和功能障礙,使抑制性(或抑制-誘導)T細胞失衡,相應的B細胞反應過強,從而導致自身免疫。另外,由於B細胞內在異常或T細胞產生過多的刺激B細胞的淋巴因子(如白細胞介素-6),導致自身反應性B細胞發生抗原非依賴性多克隆激活,這與自身免疫反應也可能有一定關係。
 小兒自身免疫性溶血性貧血
小兒自身免疫性溶血性貧血(1)紅細胞的免疫清除:在體內,自身紅細胞首先被自身抗體調理化,然後調理的紅細胞在血循環內直接被破壞(血管內溶血)和(或)被組織中巨噬細胞清除(血管外溶血)。調理的紅細胞被主要位於脾內、少部分位於肝內的巨噬細胞識別並清除。巨噬細胞則通過特異性IgG(特別是IgG1和IgG3)Fc段受體和C3b受體與包被有IgG和(或)C3的紅細胞相互作用。至少要有兩個IgG分子結合到紅細胞表面,才能引發C3b在紅細胞膜的沉積過程。IgG亞類不僅在巨噬細胞Fc受體與調理的紅細胞結合當中起重要作用(IgG3>IgG1),而且也是補體活化所必需的。
IgG亞類激活補體的作用強弱依次為:IgG1>IgG3>IgG2>IgG4。紅細胞膜上IgG和C3b同時存在可以加速紅細胞的免疫清除。與紅細胞結合的IgG的多少也可影響溶血的速度。在有些情況下,每個紅細胞上IgG分子數小於200個時仍足以引起溶血。另外,脾臟環境在免疫清除當中也有其特殊作用。在脾內緩慢的血循環中,脾竇內相對低的血漿IgG濃度可以減弱血漿IgG和包被IgG的紅細胞與Fc受體競爭性的結合,因而有利於巨噬細胞與調理的紅細胞相互作用,並有效地將其捕獲。
(2)紅細胞的損傷:巨噬細胞不僅可以直接消化調理的紅細胞,而且其表面的具有蛋白裂解活性的酶類還可以將部分紅細胞膜消化掉,從而產生球形細胞,在緩慢通過脾竇微循環時易於破裂。這是IgG包被的紅細胞(有或無C3b)發生血管外溶血的主要機制。另外,由於補體系統的調節蛋白質(C3b失活因子和β1H球蛋白)可將C3b降解為C3D,從而使調理的紅細胞表面的補體活化過程發生阻滯,紅細胞抗體得以自發釋放,包被有C3d的紅細胞得以存活,所以血管內溶血比較少見。
(3)補體參與紅細胞溶解作用:與紅細胞抗原結合後的自身抗體和補體,通過傳統補體激活途徑C1a,使被激活後產生的補體(C3b、C5b等)插入紅細胞膜內,使紅細胞膜產生內外相通的水溶性道,造成電解質的逆流和水分滲入而致紅細胞腫脹溶解。
(4)紅細胞的弱凝集作用:與自身抗體和補體結合的紅細胞,由於表面互相排斥的陰電荷減少,而引起紅細胞之間的弱凝集,凝集的紅細胞在血循環中互相衝擊,使紅細胞變形和破裂,變為球形的紅細胞在脾臟中更易被破壞,從而引起溶血。綜上所述,巨噬細胞介導的溶血機制是導致AIHA紅細胞損傷的重要機制,但是細胞毒淋巴細胞(NK細胞)的作用也不能排除,網狀內皮細胞的功能也與紅細胞的免疫清除程度有關,這可解釋病毒或細菌感染何以使病情加重。由溫抗體型所致的溶血主要為血管外溶血,當有補體參與時,也可發生血管內溶血。
冷抗體型免疫性溶血性貧血可分為冷凝集素綜合徵(cold hemagglutinin syndrome)或冷凝集病和陣發性寒冷性血紅蛋白尿;前者由病兒自身冷凝集素IgM引起,少數可由IgG或IgA引起;後者為IgG型冷抗體。這些抗體在寒冷和補體參與下與自身紅細胞發生凝集,主要在肝內破壞清除或發生血管內溶血。冷抗體型常繼發於各種感染,可能由各種病原微生物和人類紅細胞表面抗原相類似引起,所謂交叉抗原性(cross antigenicity);也有人認為病原微生物代謝產物在體內與紅細胞膜的蛋白質結合,使蛋白變性,成為一種新的抗原,因而刺激人體免疫系統產生自身抗體。
冷凝集素病:IgM冷凝集素在適宜的低溫條件和補體的參與下,能與自身紅細胞發生凝集而引起血管內溶血。冷凝集素的熱幅度(紅細胞發生凝集所需最低溫度)與凝集素的效價有關。各病例冷凝集素熱幅度不盡相同,臨床表現也有所不同。冷溶血素溶血。在低溫(16℃以下)時,此抗體與自身紅細胞膜上的P血型抗原結合,復溫時補體傳統途徑被激活,生成的C3b附著在紅細胞膜上,多聚C9膜攻擊複合體直接導致紅細胞膜損傷,離子滲漏,特別是鉀離子喪失、鈉離子進入紅細胞內,最後紅細胞腫脹而溶血。 AIHA還可與免疫系統增生性疾病並發,如淋巴細胞白血病、惡性淋巴瘤等。此外,在膠原血管疾病中也常有AIHA發生。
症狀體徵
小兒自身免疫性溶血性貧血的臨床表現隨病因和抗體類型的不同而有所不同,小兒患者以急性型多見,與成人患者多為慢性型不同。
1.溫抗體型
(1)急性型:占70%~80%,患者多為嬰幼兒,偶見於新生兒,發病年齡高峰約為3歲,以男性占多數。發病前1~2周常有急性感染病史。起病急驟,伴有發熱,寒戰、進行性貧血、黃疸、脾腫大,常發生血紅蛋白尿。少數患者合併血小板減少,出現皮膚、黏膜出血。臨床經過呈自限性,起病1~2周后溶血可自行停止,3個月內完全康復者占50%,最長不超過6個月。嚴重溶血者,可發生急性腎功能不全,出現少尿、無尿和氮質血症等。急性型者對腎上腺皮質激素治療的療效較好,預後一般良好,大多能完全恢復,但合併血小板減少者,可因出血而致死亡。
小兒自身免疫性溶血性貧血
小兒自身免疫性溶血性貧血(3)慢性型:患者絕大多數為學齡兒童。以原發性者占多數,偶爾繼發於系統性紅斑狼瘡等結締組織病。起病緩慢,病程呈進行性或間歇發作溶血,反覆感染可加重溶血。主要症狀為貧血、黃疸、肝脾腫大,常伴有血紅蛋白尿。這些症狀常反覆發作,溶血可持續數月或數年。原發性者的病程可長達10~20年;繼發性者的預後視原發病而定,合併感染可加重病情,血小板減少者預後大多嚴重,甚至出現溶血危象。常並發其他血細胞成分異常,如合併中性粒細胞或血小板減少(Even綜合徵)。腎上腺糖皮質激素療效不肯定,病死率在10%左右,主要見於伴有全身性疾病的病例。
2.冷抗體型
(1)冷凝集素病:急性患者多為5歲以下小兒,常繼發於支原體肺炎、傳染性單核細胞增多症、巨細胞病毒感染等,鉤端螺鏇體病和水痘也可發生。起病急驟,主要表現為肢端發紺和雷諾征,伴程度不等的貧血和黃疸。臨床經過呈自限性。原發病痊癒時,小兒自身免疫性溶血性貧血亦隨之痊癒。慢性型患者主要見於50歲以上的老年人,大多為原發性,亦可繼發於紅斑性狼瘡和慢性淋巴結炎,病情經過緩慢,常反覆發作,預後嚴重。
(2)陣發性冷性血紅蛋白尿症(paroxysmal cold hemoglobinuria,PCH):在我國不少見,1歲以後小兒均可發病,多繼發於先天性梅毒、麻疹、腮腺炎、水痘等疾病,少數為原發性。病兒受冷後發病,大多起病急驟,突然出現急性血管內溶血,表現為發熱、寒戰、腹痛、腰背痛、貧血和血紅蛋白尿。偶伴雷諾征。大多持續數小時即緩解,緩解後;若再受冷,可復發。 根據有溶血的臨床表現,抗人球蛋白試驗陽性,即可作出診斷。診斷成立後,還應進一步確定是原發性或繼發性。對此,可結合臨床表現進行考慮。在有些繼發性AIHA患者,其原發病常在出現溶血性貧血之後才出現,因此,長期追蹤觀察,可及時發現原發病。
此外,血清學檢查結果也可能有助於原發性與繼發性AIHA的鑑別。一般而論,IgG型多見於慢性原發性患者,而IgM型與補體型多見於繼發性患者。對於抗人球蛋白試驗陰性的可疑病例,其診斷依據主要依靠臨床表現和腎上腺糖皮質激素的治療反應來判斷。如用腎上腺糖皮質激素後有效,結合臨床上亦可考慮小兒自身免疫性溶血性貧血。冷凝集素病和PCH的診斷,除根據臨床表現和抗人球蛋白試驗外,前者冷凝集素試驗陽性,後者冷熱溶血試驗陽性,均具有確診意義。
治療方法
小兒自身免疫性溶血性貧血的治療首先應明確是繼發性還是原發性。對於繼發性患者,應首先治療其原發病。當原發病被控制後其溶血過程將隨之而緩解。但是,無論是原發性或繼發性AIHA,總的治療措施均包括糾正貧血和消除抗體的產生兩個方面。對於冷抗體型患者還應注意防寒保暖。主要治療方法如下:
1、一般治療 積極控制原發病,防治感染,以免引起溶血危象。危重病例需注意水電解質平衡及心腎功能,溶血危象者宜採取鹼化尿液的措施,套用低分子右鏇糖酐以防DIC發生等。
 小兒自身免疫性溶血性貧血
小兒自身免疫性溶血性貧血3、中醫治療 解放軍第309醫院第一分院血液病診療中心專家以中醫解毒祛濕療法治療小兒自身免疫性溶血性貧血,小兒自身免疫性溶血性貧血是由於機體免疫功能紊亂,產生了能破壞自身紅細胞的抗體,導致大量紅細胞在體內破壞,以貧血、黃疸為主要特徵的疾病,臨床表現為頭暈、心慌、氣短、乏力,面色發黃,小便深黃,部分病人可見眼球發黃。實驗室檢查主要是紅細胞減少、血色素降低、網織紅細胞明顯升高、血清膽紅素增多、抗人球蛋白試驗陽性、淋巴亞群失調,研究室科研人員認為小兒自身免疫性溶血性貧血屬中醫“黃疸”、“血疸”範疇,是濕毒之邪內蘊所致。治療上首先要祛除病因,然後採取中西醫結合的方法治療,提出“從脾論治”的基本觀點,運用清熱解毒、健脾化濕中藥湯劑配合“地黃止血膠囊”,可起到調節免疫,減少紅細胞抗體產生,迅速控制溶血,促進血液再生的作用,經過一段時間的鞏固治療,一般患者均可恢復正常。
4、輸血 輸血應慎重,因為對溫抗體型者輸血後可因輸入補體而引起溶血反應,而且血型鑑定與交叉配血在本病患者往往有困難,這是因為紅細胞表面的抗原位點被自身抗體阻斷所致。為糾正嚴重貧血而需要輸血時,宜輸入紅細胞。每次輸入的濃縮紅細胞量以100ml為宜,為減少補體作用,可用經生理鹽水洗滌後的同型紅細胞。輸血速度宜緩慢,並密切觀察病情,檢查患者血清若發現游離血紅蛋白增多,應立即停止輸血。
5、血漿置換 在正常人,血漿置換1~1.5個血漿容積,可有效降低血清IgG水平約50%。但由於抗體持續產生和大量IgG分布在血管外,從而限制了血漿置換的療效。
鑑別診斷
在鑑別診斷上小兒自身免疫性溶血性貧血應與其他溶血性貧血如珠蛋白生成障礙性貧血、溶血尿毒綜合徵、血栓性血小板減少性紫癜、傳染性單核細胞增多症合併溶血等鑑別。冷性抗體型需與陣發性睡眠性血紅蛋白尿鑑別,後者Ham及Rous試驗陽性、抗人球蛋白試驗陰性。
並發疾病
小兒自身免疫性溶血性貧血常有急性感染,進行性貧血、黃疸、脾腫大;常發生血紅蛋白尿,重者並發急性腎功能衰竭;可並發脾功能亢進;少數並有血小板減少、皮膚、黏膜出血,可因出血而致死亡;冷抗體型可並發雷諾徵象等。
檢查化驗
1.溫抗體型
(1)外周血象:急性型患者常有較重貧血,慢性型和亞急性型患者的貧血大多較輕。大多數病例血紅蛋白<60g/L,球形和嗜多色性紅細胞多見。急性型的網織紅細胞常>10%,慢性型者有時減少,主要原因是IgG抗體可以與幼紅細胞和網織紅細胞結合,使骨髓中的幼紅細胞和網織紅細胞減少,亞急性型者多輕度增加,再障危象時網織紅細胞可極度減少。白細胞總數通常升高,可出現類白血病反應。如無Even綜合徵時,血小板通常正常。
(2)紅細胞滲透脆性試驗:發病病情進展時脆性增高,症狀緩解時可正常。
 小兒自身免疫性溶血性貧血
小兒自身免疫性溶血性貧血(4)抗人球蛋白試驗(Coombs′ test):此試驗結果陽性是診斷本病的重要依據。本試驗分為直接試驗(direct antiglobulin test,DAT)和間接試驗(indirect antiglobulin test,IAT),前者是測定吸附於紅細胞表面的不完全抗體,後者是測定血清中游離的不完全抗體。小兒自身免疫性溶血性貧血這兩種試驗大多呈陽性,但極少數患者(2%~4%)試驗結果始終陰性。這種情況的發生主要與抗人球蛋白試驗的敏感性不強有關。
當每個紅細胞表面附著的IgG分子為40~200個時,已可引起溶血,但由於IgG分子數量不足,直接試驗可呈陰性反應。只有當每個紅細胞表面的IgG分子達到200~500個以上時才能測出陽性結果。為了提高本試驗的靈敏度,目前已有人套用放射免疫或補體結合抗體消耗試驗等測定紅細胞表面每一個IgG分子,以證實本病的診斷。此外,本試驗陰性也與所用抗人球蛋白試劑的局限性有關,這是因為有0.5%~2.5%的患者僅有IgA自身抗體而無IgG和IgM抗體,對於這些極少數病例,可用其抗人球蛋白IgA特異血清直接檢測。
(5)酶處理紅細胞凝集試驗:將經胰蛋白酶、木瓜蛋白酶或鳳梨蛋白酶處理的Rh基因型的O型紅細胞分別與病人血清孵育,發生凝集反應者說明病人血清中存在抗紅細胞游離抗體。溫性自身溶血素(IgM)可使酶處理紅細胞直接溶解。
(6)骨髓象:骨髓紅系統明顯增生。
2.冷凝集病
(1)血象:輕至中度貧血,血塗片:紅細胞形態可正常。
(2)冷凝集素試驗:小兒自身免疫性溶血性貧血患者的血液中含有冷凝集素(絕大多數為IgM,僅極個別為IgA或IgG),在寒冷和補體參與下,冷凝集素與自身紅細胞發生凝集。本試驗陽性是診斷本病的重要依據。在4℃本試驗滴度增高,效價可高達1∶1000以上,少數患者在2~5℃時其效價為1∶(16~256)。溫度接近體溫時凝集現象則消失。
(3)直接抗人球蛋白試驗:陽性。
3.陣發性冷性血紅蛋白尿症
(1)血象:具有典型血管內溶血的血液學檢查結果。
(2)尿:反覆發作者出現含鐵血黃素尿。
(3)冷熱溶血試驗陽性:小兒自身免疫性溶血性貧血患者的血清中含有自身冷溶血素(屬非凝集素性IgG),是抗紅細胞的自身冷抗體。當患者全身或局部處於16℃以下時,冷抗體與自身的紅細胞相結合;然後加入與病人紅細胞血型相配的血清或豚鼠血清(提供補體),當溫度升至37℃時,即發生溶血。本試驗陽性是診斷本病的重要依據。
(4)直接抗人球蛋白試驗:血紅蛋白尿發作時,常呈現陽性,溶血發作間期為陰性。 常規做X線胸片、B超和心電圖等檢查,其他根據臨床需要選擇。
預防保健
生活調理:感染、勞累、精神刺激等常常成為該病發生急性溶血的誘因,生活調理至關重要,要起居有常,隨氣候的變化及時的增減衣服,避免外感。
飲食調理:本病病機為虛夾雜,病及多為氣血兩虧,腎則脾腎俱虛,平素以虛為主或虛中夾實。禁忌生冷瓜果以免損傷脾胃,辛辣滋補之品亦當避免或少食,時時顧護脾胃。
精神調理:正確對待疾病、避免重體力勞動。避免精神緊張、調情致,勿激動,可適當鍛鍊,以增強體質,但氣血虧虛者勿練氣功,以免動氣耗血,加重氣血虛。
